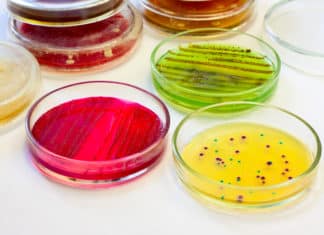
Boost or Bust? Scientists find Potential Weapon against Antibiotic Resistance Boost or Bust? Scientists find Potential Weapon against Antibiotic Resistance

J&K Goes Bananas: IIIM, CSIR Joint Endeavour Allows for Successful Cultivation...
IIIM, CSIR Joint Endeavour Allows for Successful Cultivation
A new biotechnology driven programme has been brought to J&K for commercial cultivation of banana.
“Experimental works...
Boost or Bust? Scientists find Potential Weapon against Antibiotic Resistance
Scientists find Potential Weapon against Antibiotic Resistance
Resistance to antibiotics by bacteria and other microbes is an ongoing public health crisis, contributing to about two...
BIRAC Sets up AcE Fund to Help Accelerate Growth in Biotechnology
BIRAC Sets up AcE Fund to Help Accelerate Growth in Biotechnology
Biotechnology including medical technologies industry has the power to provide solutions to myriad challenges...
Advanced Virology Institute to be established in Kerala by 2018
Advanced Virology Institute to be established in Kerala by 2018
An ambitious initiative of the state government, the 'Institute of Advanced Virology' (IAV), will soon...
Study Pinpoints Pathway to Muscle Paralysis in Fatal Muscle Degeneration Disease
Pathway to Muscle Paralysis in Fatal Muscle Degeneration Disease
ALS—the disease popularly associated with Lou Gehrig, Stephen Hawking, and the Ice-Bucket Challenge- is a neurodegenerative...
Download Admit Card For CSIR NET DEC – 2017 Exam
Dear Candidates,
CSIR NET June 2017 admit cards has been announced by CSIR HRDG and You can download your admit card for Dec 2017 CSIR NET...
This Not-So-Simple Mollusc Has 200 Eyes Collectively Functioning Like a Telescope
Mollusc Has 200 Eyes Collectively Functioning Like a Telescope
Unless you are an avid scuba diver, when you think of scallops, you probably think of...
India, Cuba Ink MoU to Enhance Cooperation in Health Sector
India, Cuba Ink MoU to Enhance Cooperation in Health Sector
India and Cuba have now signed a memorandum of understanding (MoU) to enhance cooperation in...
Study: Seaweed Found to Reduce Cancer Growth Rate
Study: Seaweed Found to Reduce Cancer Growth Rate
A breakthrough research has now confirmed that two unique compounds extracted from specific seaweed have significant cancer-inhibiting...
Chinese Scientists Identify Single Population of Bats Possessing all “Ingredients” for...
Single Population of Bats Possessing all “Ingredients” for SARS Epidemic
Bats are shoddy as it is.
Just as researchers feared, the virus behind the deadly severe...
An Element of Surprise: Study Makes Way for Entirely New Uranium-Derived...
Study Makes Way for Entirely New Uranium-Derived Materials
Uranium has largely been relegated to nuclear energy and weapons development, but researchers from the University of...
Novel Breakthrough Migraine Drug Halves Length of Attacks
Novel Breakthrough Migraine Drug Halves Length of Attacks
Migraines are characterised by an intense, throbbing headache, sensitivity to light and noise, nausea, vomiting, low energy,...
Is That Diet Working Out Alright? Your Jeans… Wait, Genes Have...
Is That Diet Working Out Alright? Your Jeans Wait,Genes Have An Opinion
Ugh! Why can’t pizza and ice cream be low-calorie?!
You know the drill when...
Smartphone Addition Found To Display an Imbalance in Brain Chemistry: Study
Smartphone Addition Found To Display an Imbalance in Brain Chemistry
Agreeably, smartphones are magical.
A device that’s small enough to fit in your pocket (at least...
The US Military Is Developing a “Genetic Doomsday” Weapon to Wipe...
US Military to develop “Genetic Doomsday” Weapon to wipe Entire Species
Our understanding of the natural world is now so great we can manipulate the...
“Resolvin” Cancer by Clearing Accumulated Debris of Tumour Cells
“Resolvin” Cancer by Clearing Accumulated Debris of Tumour Cells
One of the reasons that cancer is so hard to beat is the way that it...
Novel Photosynthesis Mimicking Device Could Pave Way for Greener Plastics
Photosynthesis Mimicking Device Could Pave Way for Greener Plastics
Ethylene, which is the building block of polyethylene, is an important chemical feedstock produced in large...
Intending to Target Endometrial Cancer Researchers Design Nanoparticles Loaded with Drugs
Endometrial Cancer Researchers Design Nanoparticles Loaded with Drugs
Endometrial cancer is that which begins in cells of the endometrium, which is the inner lining of...
Bacterial “Bond”: Biologists Engineer Enzyme Teaching Bacteria to Build Boron-Carbon Bonds...
Biologist Engineer Enzyme Teaching Bacteria to Build BoronCarbon Bonds
In a milestone research project, bioengineers at Caltech have, for the first time, developed bacteria that can...
Revolutionary Handheld Disease Diagnostic Systems – Graphene Tweezers
Graphene, a material made of a single layer of carbon atoms, was discovered more than a decade ago and has enthralled researchers with its...